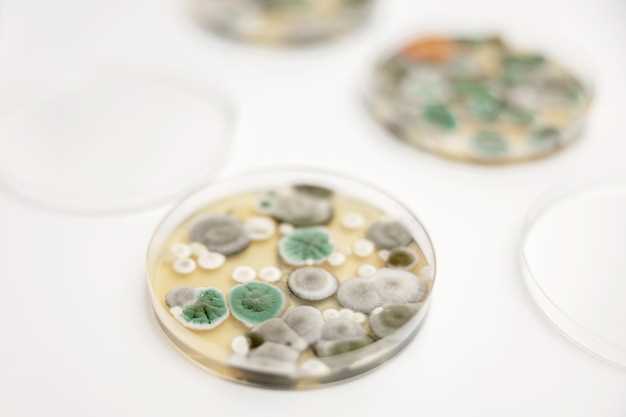
Possible Interactions

Pantoprazole soho
2026-03-17Looking for effective relief from heartburn and acid reflux? Look no further! Pantoprazole soho is here to help.
Our advanced formula provides fast and long-lasting relief, so you can get back to enjoying your favorite foods without discomfort.
Try Pantoprazole soho today and experience the difference for yourself!
Possible Interactions
It is important to be aware of possible interactions when taking Pantoprazole. This medication may interact with other drugs or substances, leading to potential side effects or reduced effectiveness.
| Interaction | Effect |
|---|---|
| Anticoagulants (blood thinners) | Pantoprazole may increase the effects of anticoagulants, leading to a higher risk of bleeding. |
| Antifungal medications | Combining Pantoprazole with certain antifungal drugs may decrease the effectiveness of both medications. |
| Antidepressants | Interaction with certain antidepressants may result in increased side effects such as dizziness or confusion. |
It is essential to inform your healthcare provider about all medications, supplements, and herbal products you are taking before starting Pantoprazole to prevent potential interactions.
Possible Interactions
When taking Pantoprazole, it is important to be aware of potential interactions with other medications. It is recommended to consult with a healthcare provider or pharmacist before using Pantoprazole alongside other drugs.
Common interactions:
- Anticoagulants such as Warfarin
- Antifungal medications like Ketoconazole
- Antivirals including Atazanavir
These are just a few examples, and there may be other medications that can interact with Pantoprazole. It is essential to disclose all medications and supplements you are taking to your healthcare provider.
Online Availability

Testimonials and Feedback
Read what our satisfied customers have to say about Pantoprazole Soho:
John W. - Pantoprazole Soho has been a lifesaver for me. It has helped me manage my acid reflux symptoms effectively.
Lisa R. - I've been using Pantoprazole Soho for a few months now, and I've noticed a significant improvement in my digestive health. Highly recommend!
Michael S. - I was skeptical at first, but Pantoprazole Soho has exceeded my expectations. I feel so much better after taking it.
Note: Testimonials are provided by real customers and have been edited for clarity.